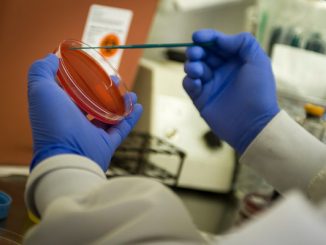

Shark Attacks Boy Swimming In Lake Pontchartrain Near New Orleans
According to a report from NOLA.com, “A shark bit a Lakeview boy swimming with his family in Lake Pontchartrain Friday afternoon. The attack happened off of Southshore Harbor. Shelly Trentacosta said her family had borrowed […]